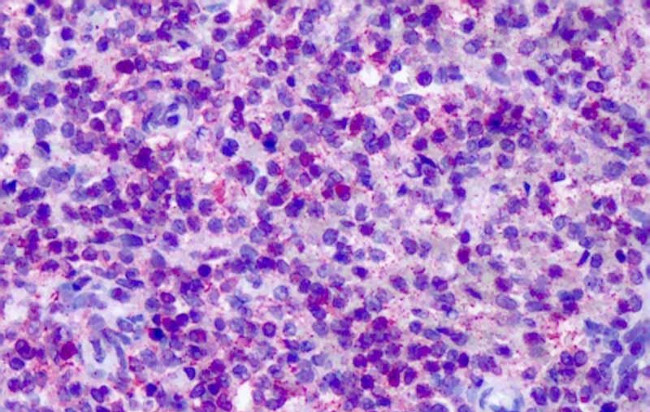
CNR2 Antibody in Immunohistochemistry (Paraffin) (IHC (P))

Search
Invitrogen
CNR2 Polyclonal Antibody
{{$productOrderCtrl.translations['antibody.pdp.commerceCard.promotion.promotions']}}
{{$productOrderCtrl.translations['antibody.pdp.commerceCard.promotion.viewpromo']}}
{{$productOrderCtrl.translations['antibody.pdp.commerceCard.promotion.promocode']}}: {{promo.promoCode}} {{promo.promoTitle}} {{promo.promoDescription}}. {{$productOrderCtrl.translations['antibody.pdp.commerceCard.promotion.learnmore']}}
产品信息
PA5-33444
种属反应
宿主/亚型
分类
类型
抗原
偶联物
形式
浓度
规格
纯化类型
保存液
内含物
保存条件
运输条件
RRID
产品详细信息
Percent identity with other species by BLAST analysis: Human, Gorilla, Gibbon, Monkey (100%) Marmoset (94%) Mouse (88%) Rat, Elephant, Bovine, Horse (82%).
靶标信息
Cannabinoids exert their well known physiological effects through two G protein coupled receptors, cannabinoid receptor 1 (CB1) and CB2. Both cannabinoid receptors have been shown to inhibit adenylyl cyclase as well as stimulate the mitogen-activated protein kinase, MAPK. CB1 receptors also modulate ion channels through direct G-protein interactions. Delta 9-tetrahydrocannibinol and related ligands likely exert their psychoactive effects by inhibiting presynaptic N- and P/Q type calcium channels. CB2 is thought to function primarily in the immune system although it has been suggested to be present in the central nervous system, including the retina.
仅用于科研。不用于诊断过程。未经明确授权不得转售。
篇参考文献 (0)
生物信息学
蛋白别名: Cannabinoid Receptor 2; cannabinoid receptor 2 (macrophage); CB-2; CB2R; CNR3; CX5; HCB2; HGNC:2160; OTTHUMP00000044841; RP11-4M23.1
基因别名: CB-2; CB2; CB2A; CB2B; CNR2; CX5
UniProt ID: (Human) P34972
Entrez Gene ID: (Human) 1269